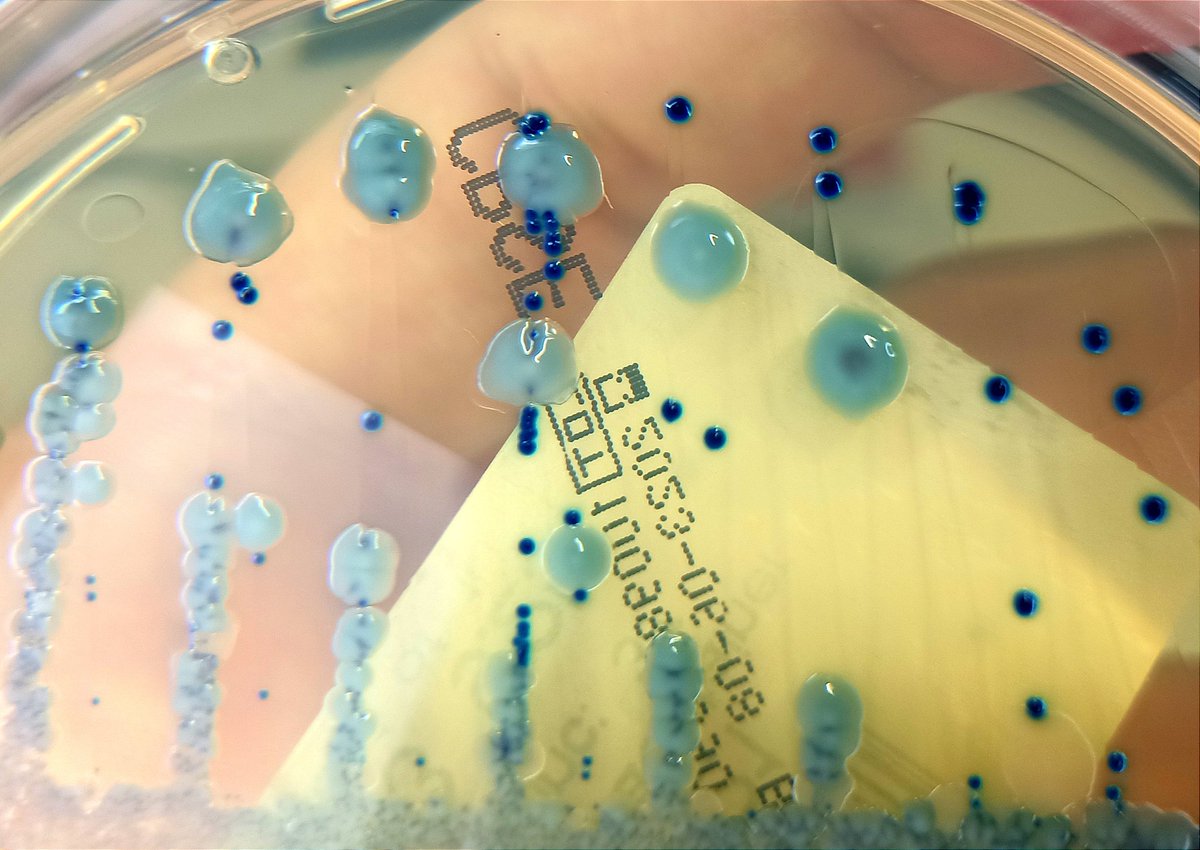
Ander González-Sarría tweet media

Sabitlenmiş Tweet
Alejandro Cobos
286 posts

Alejandro Cobos
@AlejandroCobosF
Médico. Adjunto Microbiología Clínica y Enfermedades Infecciosas en el Marañón. No se puede entender lo uno sin lo otro.
Katılım Kasım 2021
571 Takip Edilen429 Takipçiler

@PROAmacarena @HUVMacarena Paso de barreras/adónde llega el fármaco?
Español

Aquí una pequeña pista sobre la temática de la Jornada del Uso Prudente de Antimicrobianos de este año.
¿QUIÉN SE ANIMA A INTENTAR ADIVINARLO?
📆 La fecha será el próximo miércoles 29nov
🕗8 am
📍Aula Magna @HUVMacarena

Español

@guiaprioam @_rocioalma @HospitalUVRocio @InfMicHUVR @FarmaciaHUVR @MedInternaHUVR @pediatriaHUVR @ucihuvr @CirugiaHUVR @NeumoHUVR @HematoHUVR @UCIPedHUVR Buenas, va a estar online?
Español

Esta semana en la sesión mensual del PRIOAM, @_rocioalma nos enseña a simplificar el espectro del tratamiento antibiótico.
Estáis invitados a nuestra sesión en:
📆 Jueves 9 de noviembre, 8:15h.
📍 Aula 4, Edificio de Gobierno en @HospitalUVRocio

Español

🧠El cerebro de un especialista en #Microbiologia es un mundo fascinante.
🦠¿Qué otras áreas se te ocurren?
🤳¡Comparte tus ideas!

Español

@dralicehan @wwrighID @GERMANESPARZA_ @EB_Hirsch @OncIDPharmd @ClancyNeil @IdVilchez @DrToddLee @mmPharmD @JGPharmD @ErinMcCreary I would do TMP-SMX + Tigecycline and E-test for meropenem-vaborbactam. If S probably TMP-SMX+M/V.
English

#IDTwitter
Necrotizing pneumonia w/👇organisms from BAL.
Acute renal failure.
1. Have you seen KPC+ PCR, R to ceftazidime-avibactam?
2. How would you tx?
@wwrighID @GERMANESPARZA_ @EB_Hirsch @OncIDPharmd @ClancyNeil @IdVilchez @DrToddLee @mmPharmD @JGPharmD @ErinMcCreary


English

@ABsteward 7 days? Most blood cultures are discarded after 5 days unless you ask the microlan
English

🆕️⚡️⚡️Case series of 105 patients
Clinical Characteristics and Outcomes of Patients With Cutibacterium acnes Endocarditis
70 patients(66.7%) did not experience fever prior to hospital admission
The median time to (+) blood culture results was 7d
#IEWiki
jamanetwork.com/journals/jaman…
English

@ABsteward What % of them had only one set of blood cultures positive? 🙄
English

@BJegorovic @dralicehan @ABStewardess @BradSpellberg @IdVilchez @AntibioticDoc If not a class B, cazavi
English

#IDTwitter A 80-years old patient with dysuria and fever after Foley catheter for hip surgery found to have Klebsiella pneumoniaein urine culture (R to all, I colistin, S fosfo). How would you treat this monster? @dralicehan @ABStewardess @BradSpellberg @IdVilchez @AntibioticDoc

English

@ander_sarria Terapia combinada daptomicina + ertapenem quizás? Los hemos no han pitado?
Español

Supongamos que se define el foco infeccioso como pielonefritis aguda. Se avisa a Medicina Preventiva para medidas de aislamiento. El antibiograma, más difícil de lo habitual, apunta a necesidad de terapia combinada, ¿nos interesaría analizar la susceptibilidad de algún otro 💊?
Alcalá de Henares, Spain 🇪🇸 Español

Un viernes no es viernes si no surge un imprevisto poco rato antes de cerrar el chiringuito.
En urocultivo🧫 procedente de planta de hospitalización se aíslan las siguientes 🦠
🔘 Klebsiella pneumoniae BLEE
🔵 Enterococcus faecium portador de gen vanA
Antibiograma comprobado:

Alcalá de Henares, Spain 🇪🇸 Español

@ander_sarria @felipfalciparum Si en vez de un Enterobacter fuera una enterobacteria sin AmpC a lo mejor me la jugaría a aztreonam como monoterapia para la metalo. Teniendo AmpC, aunque el aztreonam sea inductor débil, me deja más tranquilo asociarle cazavi.
Español

En bacteriemia probablemente 2aria a sobreinfección de lecho quirúrgico post-amputación🦵 con evolución desfavorable, se aísla cepa de Enterobacter cloacae🦠 con el siguiente antibiograma.
¿Qué os sugiere y cómo lo manejaríais? 🧑⚕️👩🔬
P.D.: la manaza es de @felipfalciparum


Alcalá de Henares, Spain 🇪🇸 Español

@1797Angel @InfMicHUVR @guiaprioam Genial, y con respecto a los UC con dos aislados en recuento, trabajáis ambos sistemáticamente? Porque nosotros actualmente lo hacemos, supone como un 20% de los UC positivos y nos lo estamos planteando porque contribuye mucho a las bacteriurias asintomáticas mal tratadas...
Español

@AlejandroCobosF @InfMicHUVR @guiaprioam En orinas de Atención Primaria, sí. Fuera de E. coli la indicación de fosfomicina oral para tratar ITU es dudosa, y además no hay punto de corte.
Español

📢📢 ¡¡Ya tenemos disponible los antibiogramas acumulados de 2022!! Lo puedes encontrar directamente en @guiaprioam 👇👇
guiaprioam.com/section/sensib…

Español

@JulienPrvost5 @IDiots_pod @sebpoule @DrToddLee @BradSpellberg What a Micro laboratory...They should be reporting levo for S.aureus...
English

@IDiots_pod @sebpoule @DrToddLee @BradSpellberg I asked the lab and they said no… I was so overwhelmed that I did not argue. They said « don’t use Cipro for staph aureus » . I just hung up.
English

Diabetic foot osteomyelitis; wanting to switch to PO treatment and discharge patient. Combine CIPRO and like Cefadroxil ? #IDTwitter @sebpoule @DrToddLee @BradSpellberg

English

Excellent sessions, excellent @BSACandJAC @gardp_amr
meeting
🔥 Session 5
Zoliflodacin gonorrhoea
AMR in India
#ACC2023 #IDTwitter


English

@ABsteward @ASHE_Journal Any idea of what percentage of bla(-) H.influenzae were susceptible to ampicillin/amoxicillin?
English

As stewards, we love nudge ideas!
Respiratory culture nudge improves antibiotic prescribing for Moraxella catarrhalis and Haemophilus influenzae lower respiratory tract infections
5f increased🔼 odds of optimal de-escalation @ASHE_Journal #IDTwitter
cambridge.org/core/journals/…

English

@JoshHerigon @IdVilchez @BradSpellberg @mteresacgil @JuliaSerranoLo1 or aplied to the Microbiology field...e.g the read says "pneumonia" therefore I feel Iike I *have* to FilmArray it 🤣🤣
English

@BradSpellberg @ABsteward @DrToddLee Do they mean a more comfy option (long-acting) for fluco-R isolates? 🤔
English

@ABsteward @DrToddLee I’m not sure what that means. How does rezafungin provide an option if the other echinos dont? Am i missing something?
English

🔥BREAKING🔥
FDA Advisory Committee AMDAC Voted 14Y-1N that overall benefit-risk is favorable for the use of Rezafungin for treatment of candidemia/invasive candidiasis in adults with limited or no treatment options @FungalDoc @InfectiousDz
@IDstewardship
#RESTORE #IDTwitter

English

@ihartpathology WoW! 😳 No idea of this species of anerobes! Any clinical implication or just one more intestinal anaerobe?
English

Patient with a history of solid organ transplant presents with abdominal pain. Tissue findings from the stomach. Diagnosis? Answer and pearls in the comments! #PathTwitter #MedEd #microbiology

English

@transplantID Inactivation of the antibiotic when tested (most probable). AST report not corrected.
English

